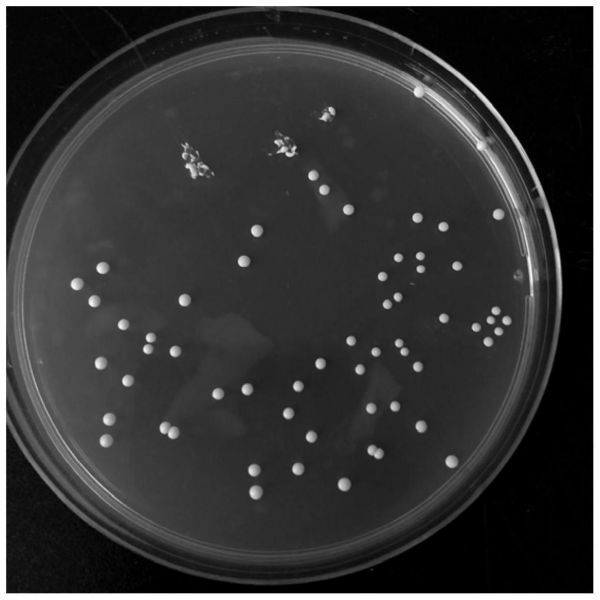
一株高利用低聚半乳糖的假小链双歧杆菌及其应用

1.本发明涉及一株高利用低聚半乳糖的假小链双歧杆菌及其应用,属于微生物技术领域以及医药技术领域。
背景技术:
2.假小链双歧杆菌是健康成年人肠道菌群中常见的双歧杆菌之一。研究发现,假小链双歧杆菌无论对慢性、低度、全身性的炎症小鼠还是急性、局部的溃疡性结肠炎小鼠的疾病活动指数和炎症反应均有改善效果,此外,还能够产生或转化叶酸、共轭亚油酸、共轭亚麻酸等多种具有生物活性的物质。假小链双歧杆菌可能具有较强的抗炎功能,作为潜能益生菌具有广阔的应用前景。
3.但是,研究发现,随着疾病的产生或者年龄的增长,体内的益生菌的含量逐渐降低,如何增加益生菌在体内的定殖,成为近年来的研究方向。
4.施用益生元是调节肠道菌群组成和代谢活性的策略之一。益生元被定义为“部分/全部不被宿主消化吸收,可使胃肠道微生物区系的组成和/或活性发生特定变化,从而为宿主的健康带来益处”。在商业上广泛应用的益生元包括菊粉、低聚果糖和低聚半乳糖等。临床实验表明,益生元(尤其是低聚半乳糖)可以促进婴儿和成人肠道中双歧杆菌的生长,使粪便样品中的双歧杆菌数量增加了2至3个对数。
5.研究发现,益生元能促进胃肠道中益生菌,如婴儿双歧杆菌、瑞士乳杆菌、两歧双歧杆菌、乳双歧杆菌、鼠李糖乳杆菌、短双歧杆菌的存活;并且,益生元能减轻胃肠道中乳铁蛋白对益生菌存活的抑制作用,益生元能保护乳铁蛋白益生菌免受胃酸和胆盐的消化,提高益生菌存活率(记载于申请号为2020109770159的中国发明专利申请文本中);然而,不同种肠道菌甚至同种不同株肠道菌对低聚半乳糖的利用情况也存在差异;例如,申请号为201010613330x的中国发明专利文本中公开了一种可快速增加乳制品中阪崎肠杆菌的数量的快速增殖剂,该增殖剂中包含了低聚葡萄糖、低聚半乳糖或低聚果糖。
6.又如,申请号为2020112240849的中国发明专利申请文本中公开了包含低聚半乳糖的保护剂可提高嗜酸乳杆菌的冻干活性。
7.以上均证明了益生元,比如低聚半乳糖能够增加益生菌在体外的增殖能力,但是,有报道表明,在补充益生元的条件下并不能够增加益生菌其在体内的定殖能力,例如,文献(alander et al.2001:effect of galacto
‑
oligosaccharide supplementation on human faecal microflora and on survival and persistence of bifidobacterium lactis bb
‑
12 in the gastrointestinal tract)公开了:补充低聚半乳糖并不能增强动物双歧杆菌乳亚种bb
‑
12在肠道中的存活或持久性。
8.因此,提供一种能够使其在肠道内定殖的假小链双歧杆菌并提高其在体内的定殖能力成为研究的热点和难点。
技术实现要素:
9.[技术问题]
[0010]
本发明要解决的技术问题是提供一株对低聚半乳糖利用能力强的且能在体内定殖的假小链双歧杆菌菌株(bifidobacterium pseudocatenulatum)及其应用。
[0011]
[技术方案]
[0012]
为解决上述问题,本发明提供了一株假小链双歧杆菌(bifidobacterium pseudocatenulatum)ccfm1170,所述假小链双歧杆菌(bifidobacterium pseudocatenulatum)ccfm1170,保藏于广东省微生物菌种保藏中心,保藏编号为gdmcc no:61548,保藏日期为2021年03月09日。
[0013]
所述假小链双歧杆菌(bifidobacterium pseudocatenulatum)ccfm1170,是来源于江苏省无锡市的健康成年人的粪便样品,该菌株经测序分析,将测序得到的序列在ncbi standard nucleotide blast中进行核酸序列比对,结果显示与双歧杆菌属假小链双歧杆菌种的核酸序列相似度为100%;结果显示菌株为假小链双歧杆菌,将其命名为假小链双歧杆菌(bifidobacterium pseudocatenulatum)ccfm1170。
[0014]
所述假小链双歧杆菌(bifidobacterium pseudocatenulatum)ccfm1170在添加了0.05%半胱氨酸的mrs固体培养基上的菌落呈乳白色圆形凸起,表面光滑、半透明状,直径为1~2mm(如图1所示);
[0015]
在本发明的一种实施方式中,施用低聚半乳糖后,原宿主肠道中的假小链双歧杆菌(bifidobacterium pseudocatenulatum)ccfm1170的相对丰度可显著提高。
[0016]
在本发明的一种实施方式中,所述假小链双歧杆菌(bifidobacterium pseudocatenulatum)ccfm1170在体外以低聚半乳糖为碳源的ycfa液体培养基中,其生长速率显著提高、代时显著缩短。
[0017]
在本发明的一种实施方式中,所述假小链双歧杆菌(bifidobacterium pseudocatenulatum)ccfm1170在与低聚半乳糖为组合的应用中,其在小鼠肠道中的定殖强度和持久性显著提高。
[0018]
在本发明的一种实施方式中,所述假小链双歧杆菌(bifidobacterium pseudocatenulatum)ccfm1170在单独施用时,提高了小鼠肠道中的异戊酸和戊酸含量,戊酸会抑制破骨细胞样细胞的成熟,促进成骨细胞的成熟和成骨细胞的胞外基质矿化,戊酸还能抑制nf
‑
κb p65蛋白的产生(促炎症)和增强il
‑
10mrna的表达(抗炎)。
[0019]
所述假小链双歧杆菌(bifidobacterium pseudocatenulatum)ccfm1170在与低聚半乳糖为组合的应用中,提高了小鼠肠道中的乙酸、丙酸和总短链脂肪酸含量,短链脂肪酸对于改善肠道菌群失调、维持肠上皮细胞的形态和提高肠道的生理功能等具有重要作用。
[0020]
本发明还提供了一种含有上述假小链双歧杆菌(bifidobacterium pseudocatenulatum)ccfm1170的微生物制剂。
[0021]
本发明的一种实施方式中,所述微生物制剂中,所述假小链双歧杆菌(bifidobacterium pseudocatenulatum)ccfm1170的活菌数为不低于1
×
106cfu/ml或1
×
106cfu/g。
[0022]
本发明还提供了一种改善宿主肠道健康的产品,所述产品中含有上述假小链双歧杆菌(bifidobacterium pseudocatenulatum)ccfm1170或上述微生物制剂。
[0023]
在本发明的一种实施方式中,所述产品中还含有低聚半乳糖。
[0024]
在本发明的一种实施方式中,所述产品中,假小链双歧杆菌的活菌数不低于1
×
106cfu/ml或1
×
106cfu/g。
[0025]
本发明的一种实施方式中,所述产品包含食品或药品。
[0026]
在本发明的一种实施方式中,所述食品为保健食品。
[0027]
在本发明的一种实施方式中,所述食品为使用上述假小链双歧杆菌(bifidobacterium pseudocatenulatum)ccfm1170,或上述微生物制剂的发酵剂生产得到的乳制品、豆制品或果蔬制品。
[0028]
在本发明的一种实施方式中,所述食品为含有上述假小链双歧杆菌(bifidobacterium pseudocatenulatum)ccfm1170,或上述微生物制剂的饮料或零食。本发明的一种实施方式中,所述发酵剂的制备方法为将上述假小链双歧杆菌(bifidobacterium pseudocatenulatum)ccfm1170按照占培养基总质量2~4%的接种量接种到培养基中,于37℃下厌氧培养48h,得到培养液;将培养液离心,得到菌体;将菌体用生理盐水清洗3次后用冻干保护剂重悬,得到重悬液;将重悬液采用真空冷冻法进行冻干,得到发酵剂。
[0029]
本发明的一种实施方式中,所述冻干保护剂和菌体的质量比为2:1。
[0030]
在本发明的一种实施方式中,所述冻干保护剂包含130g/l的脱脂奶粉。
[0031]
本发明的一种实施方式中,所述培养基的ph为6.8。
[0032]
本发明的一种实施方式中,所述药品含有上述假小链双歧杆菌(bifidobacterium pseudocatenulatum)ccfm1170、药物载体和/或药用辅料。
[0033]
本发明的一种实施方式中,所述药物载体包含微囊、微球、纳米粒和/或脂质体。
[0034]
本发明的一种实施方式中,所述药用辅料包含赋形剂和/或附加剂。
[0035]
本发明的一种实施方式中,所述赋形剂包含黏合剂、填充剂、崩解剂和/或润滑剂。
[0036]
本发明的一种实施方式中,所述附加剂包含增溶剂、助溶剂、潜溶剂和/或防腐剂。
[0037]
本发明的一种实施方式中,所述药品的剂型为粉剂、颗粒剂、胶囊剂、片剂、丸剂或口服液。
[0038]
本发明还提供了上述产品在提高假小链双歧杆菌(bifidobacterium pseudocatenulatum)ccfm1170的肠道定殖能力中的应用。
[0039]
有益效果
[0040]
本发明提供了一株假小链双歧杆菌(bifidobacterium pseudocatenulatum)ccfm1170,此假小链双歧杆菌(bifidobacterium pseudocatenulatum)ccfm1170具有高效利用低聚半乳糖的能力并且可在肠道内高效定殖,具体体现在:
[0041]
(1)当采用低聚半乳糖(10克/天,4周)干预后,人肠道原有的假小链双歧杆菌的相对丰度出现不同程度的变化,其中,本发明的假小链双歧杆菌ccfm1170对低聚半乳糖具有高响应,它在原宿主肠道中的相对丰度显著提高。
[0042]
(2)采用本发明的方法,从人粪便样品获得的包括假小链双歧杆菌ccfm1170在内的4个假小链双歧杆菌分离株及对照菌株假小链双歧杆菌ccfm1046这5株假小链双歧杆菌菌株,在体外以低聚半乳糖作为碳源的ycfa液体培养基中,生长特性表现不同,本发明的假小链双歧杆菌ccfm1170生长速率最快,代时最短。
[0043]
(3)益生菌定殖于肠道中是其发挥益生功能的基础。在给予小鼠本发明的假小链
双歧杆菌ccfm1170和低聚半乳糖组合4周后,与单给予假小链双歧杆菌ccfm1170相比,小鼠粪便中假小链双歧杆菌ccfm1170的数量显著提高,两周洗脱期中,持续给予低聚半乳糖后,假小链双歧杆菌ccfm1170的定殖持久性也显著提高。
[0044]
(4)假小链双歧杆菌是双歧杆菌的一种,研究发现假小链双歧杆菌具有较强的抗炎功能,还能够产生或转化叶酸、共轭亚油酸、共轭亚麻酸等多种具有生物活性的物质。给予小鼠本发明的假小链双歧杆菌ccfm1170,小鼠肠道中的异戊酸和戊酸含量显著提高;戊酸会抑制破骨细胞样细胞的成熟,促进成骨细胞的成熟和成骨细胞的胞外基质矿化,戊酸还能抑制nf
‑
κb p65蛋白的产生(促炎症)和增强il
‑
10mrna的表达(抗炎)。而给予小鼠本发明的假小链双歧杆菌ccfm1170和低聚半乳糖组合4周后,小鼠肠道中乙酸、丙酸以及总短链脂肪酸含量显著提高,短链脂肪酸有助于改善肠道菌群和稳定肠道功能。
[0045]
因此,本发明的假小链双歧杆菌ccfm1170在制备具有高定殖能力的改善宿主健康的产品(如食品、药品或保健品等)中,具有巨大的应用前景。
[0046]
生物材料保藏
[0047]
一株假小链双歧杆菌(bifidobacterium pseudocatenulatum)ccfm1170,分类学命名为bifidobacterium pseudocatenulatum,已于2021年03月09日保藏于广东省微生物菌种保藏中心,保藏编号为gdmcc no:61548,保藏地址为广州市先烈中路100号大院59号楼5楼,广东省微生物研究所。
附图说明
[0048]
图1:假小链双歧杆菌(bifidobacterium pseudocatenulatum)ccfm1170在添加了0.05%半胱氨酸的mrs固体培养基上的菌落形态特征。
[0049]
图2:低聚半乳糖干预4周,人肠道中,假小链双歧杆菌占肠道菌群的相对丰度的变化。
[0050]
图3:低聚半乳糖作为碳源的ycfa液体培养基中,5株假小链双歧杆菌菌株的生长状况。假小链双歧杆菌(bifidobacterium pseudocatenulatum)ccfm1170(来源于图2中1号样品),假小链双歧杆菌fjswxjndx3m3(来源于图2中3号样品),假小链双歧杆菌fjswxjndx9m6(来源于图2中9号样品),假小链双歧杆菌fjswxjndx16m1(来源于图2中16号样品);其中(a)生长曲线图,(b)代时;不同字母“a,b,c”表示假小链双歧杆菌菌株的代时长短具有显著性差异(p<0.05)。
[0051]
图4:动物实验的分组及处理方法,其中,符号“/”表示不做任何处理。
[0052]
图5:假小链双歧杆菌(bifidobacterium pseudocatenulatum)ccfm1170和阴性对照菌株假小链双歧杆菌(bifidobacterium pseudocatenulatum)ccfm1046在balb/c小鼠肠道中的定殖能力(包括干预4周时的定殖强度和后续洗脱2周过程中的定殖持久性);
[0053]
其中,(a)假小链双歧杆菌(bifidobacterium pseudocatenulatum)ccfm1170的定殖强度;不同字母“a,b,c,d”表示不同组别小鼠粪便中假小链双歧杆菌(bifidobacterium pseudocatenulatum)ccfm1170的数量具有显著性差异(p<0.05);
[0054]
(b)阴性对照菌株假小链双歧杆菌(bifidobacterium pseudocatenulatum)ccfm1046的定殖强度;不同字母“a,b,c”表示不同组别小鼠粪便中假小链双歧杆菌(bifidobacterium pseudocatenulatum)ccfm1046的数量具有显著性差异(p<0.05);
[0055]
(c)假小链双歧杆菌(bifidobacterium pseudocatenulatum)ccfm1170的定殖持久性;其中,“**”、“***”表示洗脱期时,与不添加低聚半乳糖的实验组相比,持续给予低聚半乳糖的实验组小鼠粪便中假小链双歧杆菌(bifidobacterium pseudocatenulatum)ccfm1170的数量具有显著性差异,分别为(p<0.01)和(p<0.001),“ns”表示无显著性差异(p>0.05);
[0056]
(d)阴性对照菌株假小链双歧杆菌(bifidobacterium pseudocatenulatum)ccfm1046的定殖持久性;其中,“**”、“***”表示洗脱期时,与不添加低聚半乳糖的实验组相比,持续给予低聚半乳糖的实验组小鼠粪便中假小链双歧杆菌(bifidobacterium pseudocatenulatum)ccfm1046的数量具有显著性差异,分别为(p<0.01)和(p<0.001),“ns”表示无显著性差异(p>0.05)。
具体实施方式
[0057]
下面结合具体实施例对本发明进行进一步的阐述。
[0058]
下述实施例中涉及的低聚半乳糖购自云浮市新金山生物科技有限公司。下述实施例中所涉及的假小链双歧杆菌fjswxjndx3m3,假小链双歧杆菌fjswxjndx9m6,假小链双歧杆菌fjswxjndx16m1均为同期筛选得到的菌株,保藏于江南大学食品学院生物技术中心自有菌种库中,并且这三株菌的全基因组测序数据已在ncbi的sra数据库中公开。
[0059]
下述实施例中所涉及的阴性对照菌株假小链双歧杆菌ccfm1046保藏于广东省微生物菌种保藏中心,保藏编号为gdmcc no.60599。
[0060]
下述实施例中涉及的培养基如下:
[0061]
mmrs液体培养基:蛋白胨10g/l,牛肉膏10g/l,葡萄糖20g/l,无水乙酸钠2g/l,酵母提取物5g/l,柠檬酸氢二铵2g/l,k2po4·
3h2o 2.6g/l,mgso4·
7 h2o 0.5g/l,mnso4·
h2o 0.25g/l,吐温80 1ml/l,l
‑
半胱氨酸0.5g/l;ph为6.8。
[0062]
mmrs固体培养基:在mmrs(含l
‑
半胱氨酸的mrs)液体培养基基础上添加琼脂20g/l。
[0063]
ycfa液体培养基:蛋白胨10g/l,葡萄糖10g/l,酵母提取物2.5g/l,磷酸氢二钾0.45g/l,磷酸二氢钾0.45g/l,氯化钠0.9g/l,mgso4·
7 h2o 0.09g/l,氯化钙0.09g/l,血红素0.05g/l,l
‑
半胱氨酸1g/l,刃天青1mg/l,生物素10μg/l,钴胺素10μg/l,对氨基苯甲酸30μg/l,叶酸50μg/l,吡哆胺150μg/l,硫胺素0.05mg/l,核黄素0.05mg/l,维生素k
1 10mg/l,用碳酸氢钠调ph至6.8。
[0064]
下述实施例中涉及的检测方法如下:
[0065]
活菌数的检测方法:采用国标《gb 4789.35
‑
2016食品安全国家标准食品微生物学检测乳酸菌检测》。
[0066]
下述实施例中涉及的假小链双歧杆菌菌体的制备方法如下:
[0067]
将假小链双歧杆菌划线于mmrs固体培养基上,37℃厌氧条件下培养48h,得到单菌落;挑取单菌落接种于5ml mmrs液体培养基中,37℃厌氧条件下培养18h进行活化,连续活化两代,得到活化液;将活化液按2%(v/v)的接种量接种于mmrs液体培养基中,37℃厌氧条件下培养18h,得到菌液;将菌液经5000r/min离心15min,弃去上层培养基,得到假小链双歧杆菌菌体。
[0068]
下述实施例中涉及的粪便中假小链双歧杆菌绝对定量方法如下:
[0069]
假小链双歧杆菌活化三代后进行菌落活菌计数,同时取1ml菌悬液按照细菌基因组dna提取试剂盒(购自天根生化科技有限公司)的说明书提取纯菌dna。小鼠粪便细菌基因组dna使用粪便基因组提取试剂盒(购自美国mp公司)提取,按试剂盒说明进行操作。实验通过qpcr(实时荧光定量pcr)法测定,以循环阈值(cycle threshold,ct)和不同稀释梯度的纯菌菌落形成单位对数值(log cfu)建立标准曲线进行定量。
[0070]
本发明提供的假小链双歧杆菌ccfm1170和阴性对照菌株假小链双歧杆菌ccfm1046的qpcr引物均参考过往文献(具体公开于youn et al.2008:evaluation of the pcr method for identification of bifidobacterium species;junick et al.2012:quantification of human fecal bifidobacterium species by use of quantitative real
‑
time pcr analysis targeting the groel gene.论文当中)设计,并由上海生工进行合成,验证引物特异性后进行实验。
[0071]
最终假小链双歧杆菌ccfm1170选择的引物:上游为g020f:gacagccgtagagatat,下游引物为im3r:cggggtgctgcccactttcatg;阴性对照菌株假小链双歧杆菌ccfm1046选择的引物:上游为b_pcat
‑
f:agccatcgtcaaggagcttatcgcag,下游引物为b_pcat
‑
r:cacgacgtcctgctgagagctcac。
[0072]
实施例1:假小链双歧杆菌(bifidobacterium pseudocatenulatum)ccfm1170的筛选、菌种鉴定及培养
[0073]
具体步骤如下:
[0074]
一、低聚半乳糖干预后,人肠道中假小链双歧杆菌菌株的差异响应
[0075]
招募10名(1)近1年内没有进行腹部或肠道手术(2)近2个月内没有使用抗生素(局部用药除外)(3)近1个月内没有食用益生菌/益生元/合生元等补充剂的健康成年人,每天服用10克低聚半乳糖,为期4周。分别于实验开始前的基线期、低聚半乳糖干预2周、低聚半乳糖干预4周收集粪便样品,立即置于
‑
80℃冰箱保存直至提取粪便dna实验之前。1名志愿者实验期内使用了抗生素,1名志愿者在干预期未按规定时间采集粪便样品,其余8名志愿者完成低聚半乳糖干预实验,这8名志愿者的粪便样品用于后续实验及分析。
[0076]
通过粪便基因组提取试剂盒(购自美国mp公司)提取粪便中细菌dna,用细菌特异性引物扩增细菌16s rdna的v3~v4区,上游引物为:cctaygggrbgcascag,下游引物为:ggactacnngggtatctaat,此外,用双歧杆菌种特异性引物bif
‑
groel pcr扩增双歧杆菌groel基因,上游为bif
‑
groel
‑
f:tccgattacgaycgygagaagct,下游引物为bif
‑
groel
‑
r:csgcytcggtsgtcaggaacag。
[0077]
产物分别使用qiaquick gel extraction kit试剂盒根据说明书进行胶回收,使用qubittm dsdna br assay kit定量,根据truseq dna lt sample preparation kit的说明进行文库的构建,最后使用miseq v3 reagent kit(600cycles
‑
pe)在illumina miseq上进行上机测序。测序完成后,进行下机数据处理并将数据可视化。
[0078]
低聚半乳糖干预后,人肠道假小链双歧杆菌占肠道菌群的相对丰度(由细菌16s rdna的v3~v4区扩增及测序分析可得双歧杆菌属占肠道菌群的相对丰度,由双歧杆菌groel基因扩增及测序分析可得假小链双歧杆菌种占双歧杆菌属的相对丰度,两者相乘即为假小链双歧杆菌占肠道菌群的相对丰度,例如:某志愿者双歧杆菌属占肠道菌群30%,假
小链双歧杆菌又占双歧杆菌属的30%,那么该受试者的假小链双歧杆菌占肠道菌群的9%的变化见图2。
[0079]
由图2可知,不同人肠道中的假小链双歧杆菌对低聚半乳糖的响应差异非常大,有些个体体内的假小链双歧杆菌完全没有被刺激生长(例如2号、9号和10号个体),其他个体体内的假小链双歧杆菌被不同程度地刺激生长(例如1号、3号和16号个体),其中,1号个体体内的假小链双歧杆菌被刺激生长的程度最大,具体表现为1号个体体内的假小链双歧杆菌的相对丰度在低聚半乳糖干预后具有最大增加量。此结果表明,1号个体体内的假小链双歧杆菌对低聚半乳糖的干预具有高响应特性。
[0080]
上述提取粪便中细菌dna需用1g左右粪便样品,剩余的粪便样品用于后续假小链双歧杆菌的分离筛选实验。
[0081]
二、假小链双歧杆菌(bifidobacterium pseudocatenulatum)ccfm1170的获得
[0082]
1、筛选
[0083]
将步骤一得到的样本,混匀样本,吸取0.5ml样本加到4.5ml灭菌生理盐水进行梯度稀释,然后分别取100μl稀释梯度为10
‑4、10
‑5、10
‑6的稀释液于ph=6.8添加了莫匹罗星的mmrs固体培养基上进行平板涂布,37℃厌氧培养48h,观察并记录菌落形态;
[0084]
挑取mmrs固体培养基上不同形态的菌落进行划线分离,经37℃厌氧培养48h后,再次挑取mmrs固体培养基上不同形态的单菌落进行划线分离,直至得到形态一致的纯的单菌落;
[0085]
挑取mmrs固体培养基上的纯菌落接种于5ml mmrs液体培养基中,37℃厌氧培养18h;取1ml菌液于无菌离心管中,5000r/min离心15min后弃去上层培养基,菌泥重悬于30%甘油溶液中置于
‑
80℃中保藏,得到菌株。
[0086]
2、鉴定
[0087]
分别对分离得到的菌株菌体进行pcr扩增16s rdna,pcr产物送至金唯智(苏州)生物科技有限公司进行测序,将测序得到的结果在ncbi standard nucleotide blast中进行核酸序列比对,比对结果为假小链双歧杆菌,命名为假小链双歧杆菌ccfm1170。
[0088]
同期筛选得到了3株菌株,分别命名为:假小链双歧杆菌fjswxjndx3m3,假小链双歧杆菌fjswxjndx9m6,假小链双歧杆菌fjswxjndx16m1。
[0089]
3、培养
[0090]
分别将上述假小链双歧杆菌接入mmrs固体培养基上于37℃厌氧培养48h后,观察其菌落。发现其菌落呈乳白色圆形凸起,表面光滑、半透明状,直径为1~2mm。培养前后通过ph计测量空白培养液以及加菌的培养液的ph,发现假小链双歧杆菌在培养过程中产酸。将假小链双歧杆菌菌株接入mmrs液体培养基中,置于酶标仪中,37℃下厌氧培养48h,培养过程中,间隔1小时测量培养液的od
600
,发现假小链双歧杆菌培养18~24h达到生长稳定期。
[0091]
实施例2:低聚半乳糖作为碳源的ycfa液体培养基中,假小链双歧杆菌(bifidobacterium pseudocatenulatum)ccfm1170的生长特性
[0092]
具体步骤如下:
[0093]
(1)分别将假小链双歧杆菌ccfm1170、假小链双歧杆菌ccfm1046、假小链双歧杆菌fjswxjndx3m3、假小链双歧杆菌fjswxjndx9m6、假小链双歧杆菌fjswxjndx16m1划线于mmrs固体培养基上,37℃条件下厌氧培养48h,得到单菌落;
[0094]
挑取单菌落接种于mrs液体培养基中,37℃条件下培养18h进行活化,连续活化两代,得到活化液。
[0095]
(2)分别取1ml活化液于无菌离心管中,5000r/min离心15min后弃去上层培养基得到菌泥,再用1ml无菌生理盐水重悬菌泥,再以2%(v/v)的接种量接种于低聚半乳糖取代葡萄糖的ycfa液体培养基中(肠道微生物体外模拟培养方法),置于酶标仪中,37℃下厌氧培养48h,培养过程中,间隔1小时测量培养液的od
600
。
[0096]
结果显示:5株假小链双歧杆菌的生长曲线如图3(a)所示;5株假小链双歧杆菌的代时如图3(b)所示;其中,代时指细胞每分裂一次所需的时间;代时越短,表明生长速度越快;各菌株在对数期的代时大小可以反映其生长速率的快慢,对数期代时公式如下所示:代时=(t2‑
t1)/3.322(od2‑
od1);式中,t2为对数生长末期的时间,t1为刚进入对数生长期的时间,od2、od1为在t2、t1时刻测得的菌悬液的吸光值。
[0097]
由图3(a)可知,假小链双歧杆菌ccfm1170在对数生长期生长速率较快,且到达生长稳定期时拥有最大生长量,为od
600
为0.94
±
0.01,而假小链双歧杆菌ccfm1046、假小链双歧杆菌fjswxjndx3m3、假小链双歧杆菌fjswxjndx9m6、假小链双歧杆菌fjswxjndx16m1在稳定期时的od
600
分别为0.52
±
0.02、0.71
±
0.01、0.77
±
0.03、0.85
±
0.03;此结果表明,假小链双歧杆菌ccfm1170具有较强的低聚半乳糖利用能力,对低聚半乳糖作为碳源的ycfa培养基环境适应能力最强。而假小链双歧杆菌ccfm1046生长速率最慢,到达生长稳定期时的生长量也最小。
[0098]
此外,由图3(b)可知,相比较而言,假小链双歧杆菌ccfm1170的代时较短,即细菌繁殖一代所需的时间较短,此结果也表明,假小链双歧杆菌ccfm1170具有较强的低聚半乳糖利用能力,利用低聚半乳糖用于自身的生长繁殖,生长速率更快,代时更短。而假小链双歧杆菌ccfm1046代时最长,说明它利用低聚半乳糖能力最差。以假小链双歧杆菌ccfm1046作为阴性对照菌株,进行后续动物实验。
[0099]
实施例3:低聚半乳糖对假小链双歧杆菌(bifidobacterium pseudocatenulatum)ccfm1170定殖能力的影响
[0100]
具体步骤如下:
[0101]
将假小链双歧杆菌ccfm1170、阴性对照菌株假小链双歧杆菌ccfm1046分别接入mmrs液体培养基中于37℃厌氧培养36h后,5000r/min,15min,4℃离心收集菌泥,经生理盐水洗涤后重悬于生理盐水中,菌浓度为5
×
109cfu/ml,获得菌悬液,菌液每日现配现用。低聚半乳糖的给予剂量为0.4克/天/只小鼠,根据小鼠的平均每日饮水量溶于饮用水中,每隔5天换一次饮用水。
[0102]
将体重为20
‑
22g的spf级balb/c雄性小鼠64只,随机分为8组,每组8只,分别为:(1)control组:空白对照;(2)gos组:干预期给予低聚半乳糖;(3)ccfm1170组:干预期灌胃假小链双歧杆菌ccfm1170菌悬液;(4)gos+ccfm1170组:干预期给予低聚半乳糖且灌胃假小链双歧杆菌ccfm1170菌悬液;(5)gos+ccfm1170+gos(洗脱期)组:干预期给予低聚半乳糖且灌胃假小链双歧杆菌ccfm1170菌悬液,而洗脱期2周继续给予低聚半乳糖;(6)ccfm1046组:干预期灌胃假小链双歧杆菌ccfm1046菌悬液;(7)gos+ccfm1046组:干预期给予低聚半乳糖且灌胃假小链双歧杆菌ccfm1046菌悬液;(8)gos+ccfm1046+gos(洗脱期)组:干预期给予低聚半乳糖且灌胃假小链双歧杆菌ccfm1046菌悬液,而洗脱期2周继续给予低聚半乳糖。
[0103]
实验共7周:第1周为小鼠适应期,适应期不做任何处理,小鼠自由饮食饮水;第2周至第5周为干预期:
[0104]
ccfm1170组、gos+ccfm1170组、gos+ccfm1170+gos(洗脱期)组每只小鼠每天灌胃假小链双歧杆菌ccfm1170菌悬液200μl;ccfm1046组、gos+ccfm1046组、gos+ccfm1046+gos(洗脱期)组每只小鼠每天灌胃假小链双歧杆菌ccfm1046菌悬液200μl;control组和gos组小鼠灌胃同等剂量的生理盐水,同时gos组、gos+ccfm1170组、gos+ccfm1170+gos(洗脱期)组、gos+ccfm1046组、gos+ccfm1046+gos(洗脱期)组的饮用水中添加低聚半乳糖;第6周至第7周为洗脱期,所有组小鼠停止灌胃生理盐水或假小链双歧杆菌菌悬液,此外gos组、gos+ccfm1170组、gos+ccfm1046组的饮用水中也不再添加低聚半乳糖,仅有gos+ccfm1170+gos(洗脱期)组和gos+ccfm1046+gos(洗脱期)组的饮用水继续添加低聚半乳糖。具体实验分组及处理见图4。
[0105]
在干预期末收集各个组小鼠的粪便,在洗脱1天、洗脱3天、洗脱7天、洗脱14天收集gos+ccfm1170组、gos+ccfm1170+gos(洗脱期)组、gos+ccfm1046组和gos+ccfm1046+gos(洗脱期)组小鼠的粪便。
[0106]
经过灌胃进入小鼠肠道内的菌株,如果没有在肠道中定殖,则会因肠道蠕动随粪便一起排出体外,通常认为24小时足够将未定殖的菌株排出体外,之后再收集的粪便中的菌数即为肠道中定殖下来的菌株因新陈代谢脱落所致,可以用来表征肠道中该菌株的定殖量。因此,本实施案例对于小鼠粪便收集时间有一定要求,干预期末小鼠粪便收集时间点为距离前一天菌株灌胃过去24小时的时间点,洗脱1天即为该时间点累积24小时,洗脱3天、洗脱7天、洗脱14天以此类推。收集到的小鼠粪便进行qpcr绝对定量粪便中假小链双歧杆菌ccfm1170或阴性对照菌株假小链双歧杆菌ccfm1046的数量(结果如图5所示)。
[0107]
结果显示:干预末期,各组小鼠粪便中本发明提供的假小链双歧杆菌ccfm1170的绝对数量如图5(a)所示;干预末期,各组小鼠粪便中阴性对照菌株假小链双歧杆菌ccfm1046的绝对数量如图5(b)所示;洗脱期,gos+ccfm1170组和gos+ccfm1170+gos(洗脱期)组小鼠粪便中假小链双歧杆菌ccfm1170的绝对数量如图5(c)所示;洗脱期,gos+ccfm1046组和gos+ccfm1046+gos(洗脱期)组小鼠粪便中阴性对照菌株假小链双歧杆菌ccfm1046的绝对数量如图5(d)所示。其中,control组小鼠粪便测得的假小链双歧杆菌ccfm1170的绝对菌数作为该菌qpcr法绝对定量菌数的检出限;同理,control组小鼠粪便测得的假小链双歧杆菌ccfm1046的绝对菌数作为假小链双歧杆菌ccfm1046的qpcr法绝对定量菌数的检出限。
[0108]
由图5(a)可知,在低聚半乳糖的干预下,假小链双歧杆菌ccfm1170在肠道中的定殖量显著提高(10
7.09
±
0.18
cfu/g粪便),与未加低聚半乳糖的ccfm1170组(10
5.55
±
0.40
cfu/g粪便)相比,提高大约两个数量级(大约100倍)。
[0109]
由图5(b)可知,低聚半乳糖的干预并未提高阴性对照菌株假小链双歧杆菌ccfm1046在肠道中的定殖量,具体表现在gos+ccfm1046组(10
6.43
±
0.23
cfu/g粪便)与ccfm1046组(10
6.23
±
0.25
cfu/g粪便)相比,小鼠粪便中的绝对菌数无明显差异(p>0.05)。
[0110]
由图5(c)可知,低聚半乳糖提高了假小链双歧杆菌ccfm1170的定殖持久性,洗脱7天仍然稳定定殖于gos+ccfm1170+gos(洗脱期)组小鼠的肠道中,洗脱14天仍然能从gos+ccfm1170+gos(洗脱期)组小鼠的粪便中检测到,而洗脱期时未给予低聚半乳糖的gos+
ccfm1170组,洗脱3天定殖量就发生了明显的下降。
[0111]
由图5(d)可知,洗脱期继续给予低聚半乳糖,阴性对照菌株假小链双歧杆菌ccfm1046的定殖持久性并未提高,gos+ccfm1046组和gos+ccfm1046+gos(洗脱期)组小鼠粪便中的假小链双歧杆菌ccfm1046都在洗脱1天后显著降低,几乎降低到了检出限。
[0112]
可见,在肠道复杂环境中,本发明假小链双歧杆菌ccfm1170能够通过较强的低聚半乳糖的利用能力从而提高自身进入肠道时在肠道中竞争适应性,定殖强度显著提高,定殖持久性显著延长。
[0113]
实施例4:低聚半乳糖对假小链双歧杆菌(bifidobacterium pseudocatenulatum)ccfm1170代谢活性的影响
[0114]
具体实施方式同实施例3,在干预期末收集各个组小鼠的粪便,除了用于上述粪便中绝对菌数的测定,剩余粪便还用于短链脂肪酸种类及含量的测定,以表征菌株的代谢活性。
[0115]
具体步骤如下:
[0116]
称取3颗左右小鼠粪便冻干(记录冻干的粪便质量);加入500μl饱和nacl溶液并均质;加入40μl 10%的硫酸酸化;然后加入1ml乙醚萃取样品中的短链脂肪酸,振荡30s后离心(12000rpm,15min,4℃);吸取上清液加入0.25g无水硫酸钠除去水分;静置15min,以相同条件再次离心,取上层乙醚相加入进样瓶中,上机分析。
[0117]
gc
‑
ms条件为:rtx
‑
wax毛细管色谱柱(30m
×
0.25μm
×
0.25μm);载气为氦气,流速为2ml/min,分流比为10:1,进样量为1μl;进样温度为240℃,按如下程序进行升温:起始温度为100℃,按7.5℃/min升温至140℃,然后按60℃/min升温至200℃,保持3min,离子化温度为220℃;分析采用全扫描模式,采样外标法计算各短链脂肪酸(乙酸、丙酸、丁酸、异丁酸、戊酸、异戊酸)的浓度(μmol/g);结果如表1所示:
[0118]
表1:4周干预结束时,小鼠粪便中短链脂肪酸(乙酸、丙酸、异丁酸、丁酸、异戊酸、戊酸)以及总短链脂肪酸含量,数据表示为平均值
±
标准差。“*”表示与control组相比,该实验组小鼠粪便中该项短链脂肪酸含量具有显著差异(p<0.05)。
[0119][0120]
干预期末,各组小鼠粪便中短链脂肪酸的种类及含量如表1所示。由表1可知,与control组相比,ccfm1170组小鼠粪便的异戊酸、戊酸含量显著提高,戊酸会抑制破骨细胞样细胞的成熟,促进成骨细胞的成熟和成骨细胞的胞外基质矿化,戊酸还能抑制nf
‑
κb p65蛋白的产生(促炎症)和增强il
‑
10mrna的表达(抗炎)。
[0121]
与control组相比,gos+ccfm1170组小鼠粪便的乙酸、丙酸以及总短链脂肪酸含量显著提高。乙酸是双歧杆菌代谢产生的最常见的短链脂肪酸之一,说明低聚半乳糖提高假小链双歧杆菌ccfm1170定殖强度的同时提高了假小链双歧杆菌ccfm1170的代谢活性;丙酸是由其他肠道菌群产生的,说明假小链双歧杆菌ccfm1170的定殖调节了整体肠道菌群;总短链脂肪酸含量的显著提高有利于维持肠上皮细胞形态和肠道功能,还有益于宿主血糖调节及胰岛素敏感性的改善。
[0122]
可见,低聚半乳糖提高假小链双歧杆菌ccfm1170定殖强度的同时提高了假小链双歧杆菌ccfm1170的代谢活性,促进宿主健康。
[0123]
实施例5:假小链双歧杆菌(bifidobacterium pseudocatenulatum)ccfm1170的应用假小链双歧杆菌ccfm1170可用于制备菌粉,菌粉的具体制备过程如下:
[0124]
假小链双歧杆菌ccfm1170划线于mmrs固体培养基上,37℃条件下厌氧培养48h,得到单菌落;挑取单菌落接种于mmrs液体培养基中,37℃条件下厌氧培养18h进行活化,连续活化两代,得到活化液;将活化液按2%(v/v)的接种量接种于培养基中,37℃条件下厌氧培养18h,得到菌液;将菌液经5000r/min离心15min,得到菌泥;将菌泥用生理盐水清洗3次后用保护剂重悬至浓度为1
×
10
10
cfu/ml,得到菌悬液;将菌悬液在温度37℃下孵育60min后冻干,得到假小链双歧杆菌ccfm1170菌粉;
[0125]
其中,培养基的制备方法为:使用以培养基总重量计87.7%的水将10%酶水解脱脂乳、0.5%葡萄糖、1.5%胰蛋白胨与0.3%酵母浸膏溶解,然后调整其ph为6.8,得到培养基;
[0126]
保护剂的成分包含:130g/l脱脂奶粉。
[0127]
实施例6:假小链双歧杆菌(bifidobacterium pseudocatenulatum)ccfm1170的应用假小链双歧杆菌ccfm1170可用于制备胶囊制品,胶囊制品的具体制备过程如下:
[0128]
假小链双歧杆菌ccfm1170划线于mmrs固体培养基上,37℃条件下厌氧培养48h,得到单菌落;挑取单菌落接种于mrs液体培养基中,37℃条件下厌氧培养18h进行活化,连续活化两代,得到活化液;将活化液按2%(v/v)的接种量接种于培养基中,37℃条件下厌氧培养18h,得到菌液;将菌液经5000r/min离心15min,得到菌泥;将菌泥用生理盐水清洗3次后用保护剂重悬至浓度为1
×
10
10
cfu/ml,得到菌悬液;菌悬液添加至浓度为30g/l的海藻酸钠溶液中至浓度为2
×
109cfu/ml后,充分搅拌,使得假小链双歧杆菌ccfm1170的细胞均匀地分散于海藻酸钠溶液中,得到混合液;将混合液挤压到浓度为20g/l的氯化钙溶液中形成胶粒;待形成的胶粒静止固化30min后,过滤收集胶粒;将收集得到的胶粒进行冷冻干燥48h,得到粉剂;将粉剂装入到药用胶囊中,得到胶囊制品;
[0129]
其中,培养基的制备方法为:使用以培养基总重量计87.7%的水将10%酶水解脱脂乳、0.5%葡萄糖、1.5%胰蛋白胨与0.3%酵母浸膏溶解,然后调整其ph为6.8,得到培养基。
[0130]
实施例7:假小链双歧杆菌(bifidobacterium pseudocatenulatum)ccfm1170的应用假小链双歧杆菌ccfm1170可用于制备片剂,片剂的具体制备过程如下:
[0131]
假小链双歧杆菌ccfm1170划线于mmrs固体培养基上,37℃条件下厌氧培养48h,得到单菌落;挑取单菌落接种于mrs液体培养基中,37℃条件下厌氧培养18h进行活化,连续活化两代,得到活化液;将活化液按2%(v/v)的接种量接种于培养基中,37℃条件下厌氧培养
18h,得到菌液;将菌液经5000r/min离心15min,得到菌泥;将菌泥用生理盐水清洗3次后用保护剂重悬至浓度为1
×
10
10
cfu/ml,得到菌悬液;将菌悬液在温度37℃下孵育60min后冻干,得到假小链双歧杆菌ccfm1170菌粉;
[0132]
其中,培养基的制备方法为:使用以培养基总重量计87.7%的水将10%酶水解脱脂乳、0.5%葡萄糖、1.5%胰蛋白胨与0.3%酵母浸膏溶解,然后调整其ph为6.8,得到培养基;
[0133]
保护剂的成分包含:130g/l脱脂奶粉。
[0134]
称取假小链双歧杆菌ccfm1170菌粉25.7重量份、淀粉55.0重量份、纤维素衍生物4.5重量份、羧甲基淀粉钠12.0重量份、滑石粉0.8重量份、蔗糖1.0重量份与水1.0重量份,得到原材料;将原材料混合,得到湿颗粒;将湿颗粒用中南制药机械厂的压片机进行压片后使用青州市益康中药机械有限公司的小型药物干燥机进行干燥,得到片剂。
[0135]
实施例8:假小链双歧杆菌(bifidobacterium pseudocatenulatum)ccfm1170的应用假小链双歧杆菌ccfm1170可用于制备发酵乳,发酵乳的具体制备过程如下:
[0136]
假小链双歧杆菌ccfm1170划线于mmrs固体培养基上,37℃条件下厌氧培养48h,得到单菌落;挑取单菌落接种于mmrs液体培养基中,37℃条件下厌氧培养18h进行活化,连续活化两代,得到活化液;将活化液按2%(v/v)的接种量接种于培养基中,37℃条件下厌氧培养18h,得到菌液;将菌液经5000r/min离心15min,得到菌泥;将菌泥用生理盐水清洗3次后用保护剂重悬至浓度为1
×
10
10
cfu/ml,得到菌悬液;将菌悬液在温度37℃下孵育60min后冻干,得到假小链双歧杆菌ccfm1170菌粉;
[0137]
其中,培养基的制备方法为:使用以培养基总重量计87.7%的水将10%酶水解脱脂乳、0.5%葡萄糖、1.5%胰蛋白胨与0.3%酵母浸膏溶解,然后调整其ph为6.8,得到培养基;
[0138]
保护剂的成分包含:130g/l脱脂奶粉。
[0139]
将假小链双歧杆菌ccfm1170菌粉与商业干粉发酵剂保加利亚乳杆菌和商业干粉发酵剂嗜热链球菌按照质量比1:1:1的比例混合,得到发酵剂;将糖添加至鲜奶中至浓度为50g/l,得到混合液;将混合液在65℃、20mpa的条件下进行均质后在95℃下保温杀菌5min,得到发酵原料;将发酵原料降温至35℃后以0.03%(v/v)的接种量将发酵剂接种至发酵原料中,于35℃下保温发酵16h,得到发酵乳;将发酵乳于42℃下放置4h进行凝乳后,在4℃下冷藏24h进行后熟,得到发酵乳成品。
[0140]
实施例9:假小链双歧杆菌(bifidobacterium pseudocatenulatum)ccfm1170的应用假小链双歧杆菌ccfm1170可用于制备果蔬饮料,果蔬饮料的具体制备过程如下:
[0141]
假小链双歧杆菌ccfm1170划线于mmrs固体培养基上,37℃条件下厌氧培养48h,得到单菌落;挑取单菌落接种于mmrs液体培养基中,37℃条件下厌氧培养18h进行活化,连续活化两代,得到活化液;将活化液按2%(v/v)的接种量接种于培养基中,37℃条件下厌氧培养18h,得到菌液;将菌液经5000r/min离心15min,得到菌泥;将菌泥用生理盐水清洗3次后用保护剂重悬至浓度为1
×
10
10
cfu/ml,得到菌悬液;将菌悬液在温度37℃下孵育60min后冻干,得到假小链双歧杆菌ccfm1170菌粉;
[0142]
其中,培养基的制备方法为:使用以培养基总重量计87.7%的水将10%酶水解脱脂乳、0.5%葡萄糖、1.5%胰蛋白胨与0.3%酵母浸膏溶解,然后调整其ph为6.8,得到培养
基;
[0143]
保护剂的成分包含:130g/l脱脂奶粉。
[0144]
将新鲜水果和蔬菜洗净后榨汁,按照5g/l的比例加入食品级蛋白胨,在温度140℃下高温热杀菌2秒;将杀菌后的果蔬汁降温至约37℃后再添加本发明假小链双歧杆菌ccfm1170菌粉,至浓度为不低于1
×
106cfu/ml,得到果蔬饮料,在4℃下冷藏保存。即可得到含有本发明假小链双歧杆菌ccfm1170活菌的果蔬饮料。
[0145]
实施例10:假小链双歧杆菌(bifidobacterium pseudocatenulatum)ccfm1170的应用
[0146]
假小链双歧杆菌ccfm1170可用于制备乳饮品,乳饮品的具体制备过程如下:
[0147]
假小链双歧杆菌ccfm1170划线于mmrs固体培养基上,37℃条件下厌氧培养48h,得到单菌落;挑取单菌落接种于mmrs液体培养基中,37℃条件下厌氧培养18h进行活化,连续活化两代,得到活化液;将活化液按2%(v/v)的接种量接种于培养基中,37℃条件下厌氧培养18h,得到菌液;将菌液经5000r/min离心15min,得到菌泥;将菌泥用生理盐水清洗3次后用保护剂重悬至浓度为1
×
10
10
cfu/ml,得到菌悬液;将菌悬液在温度37℃下孵育60min后冻干,得到假小链双歧杆菌ccfm1170菌粉;
[0148]
其中,培养基的制备方法为:使用以培养基总重量计87.7%的水将10%酶水解脱脂乳、0.5%葡萄糖、1.5%胰蛋白胨与0.3%酵母浸膏溶解,然后调整其ph为6.8,得到培养基;
[0149]
保护剂的成分包含:130g/l脱脂奶粉。
[0150]
将脱脂奶在95℃杀菌20min后冷却至4℃,得到原料;在原料中添加假小链双歧杆菌ccfm1170菌粉至浓度为不低于1
×
106cfu/ml,得到乳饮品,在4℃下冷藏保存。
[0151]
虽然本发明已以较佳实施例公开如上,但其并非用以限定本发明,任何熟悉此技术的人,在不脱离本发明的精神和范围内,都可做各种的改动与修饰,因此本发明的保护范围应该以权利要求书所界定的为准。
相关知识
低聚半乳糖的作用
低聚半乳糖的生理功能及应用前景
低聚乳糖和低聚半乳糖的作用
低聚半乳糖的作用营养价值
低聚半乳糖的作用及功效乳糖不耐
低聚半乳糖对肠道益生菌作用机理的研究
低聚果糖和低聚半乳糖在乳制品中的应用
乳双歧杆菌HN019与健康
低聚半乳糖和低聚乳糖的作用
双歧杆菌如何助力婴幼儿肠道健康?
网址: 一株高利用低聚半乳糖的假小链双歧杆菌及其应用 https://m.trfsz.com/newsview780246.html